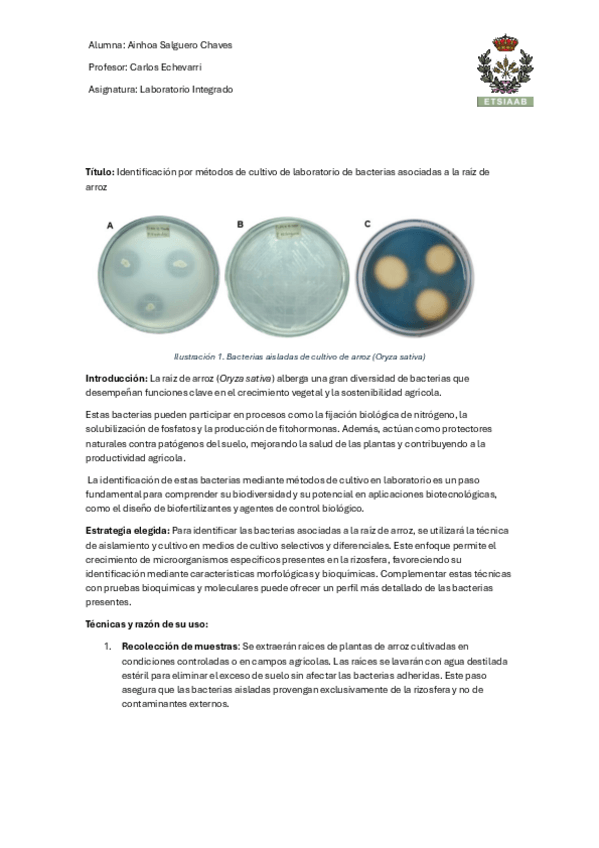

Laboratorio Integrado de Análisis Agroambiental
Todo
Trabajos
chevron_left
chevron_right
He publicado nuevos trabajos de 4º Laboratorio Integrado de Análisis Agroambiental: ACTIVIDAD-LABORATORIO-INTEGRADO-DE-ANALISIS-AGROAMBIENTAL.pdf
He publicado nuevos trabajos de 4º Laboratorio Integrado de Análisis Agroambiental: INFORME-TOXICOLOGICO-TAMARA-Y-AINHOA.pdf
He publicado nuevos trabajos de 4º Laboratorio Integrado de Análisis Agroambiental: Actividadintegradora2024TSyAS.pdf
He publicado nuevos trabajos de 4º Laboratorio Integrado de Análisis Agroambiental: TareaLaboratorioASC.pdf

¡Estás al día!
Has visto todos los archivos